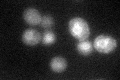

View description
C-5 sterol desaturase, catalyzes the introduction of a C-5(6) double bond into episterol, a precursor in ergosterol biosynthesis; mutants are viable, but cannot grow on non-fermentable carbon sources
Localization:
Intensity:
Fold change:
Significance:
-
C’ GFP library in SD

ER112.53 -
N' NOP1pr-GFP in SD

ER42.3527 -
N' TEF2pr-mCherry in SD

missing0 -
N' NATIVEpr-GFP in SD

missing0 -
N' TEF2pr-VC and Cyto-VN in SD

#N/A0 -
C’ GFP library in SD+DTT

ER168.421.49Yes -
C’ GFP library in SD+H2O2

ER101.490.9No -
C’ GFP library in Starvation Media
ER72.280.64Yes -
C’ GFP library on the background of Pup2-DaMP

ER -
C’ GFP library on the background of CCT mutant

ER125.7191.11709No
